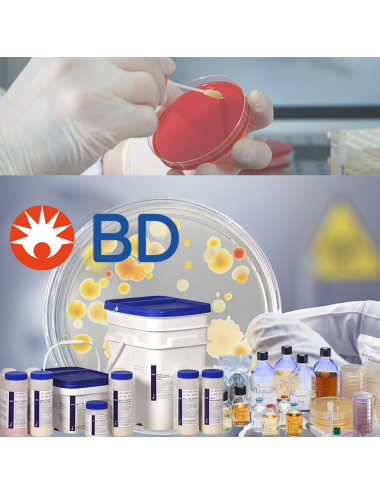
Lista de Becton Dickinson

CATEGORÍAS
Categories
- inicio
-
- MOBILIARIO
- DESCARTABLE
- Agujas y jeringas
- Bisturí, hojas, cuchillas y contenedores para cortantes
- Tiritas, vendajes y apósitos
- Criochirugía, crioterapia y termocauterios
- Curetas y punch para biopsia
- Difusores y grifos
- Desinfectantes y productos químicos
- Dispositivos de protección individual (DPI)
- Hilos de sutura
- Guantes y sábanas médicos
- Material para ginecología
- Telino quirúrgico y vestimenta
- Peeling químico
- Pruebas rápidas
- Varios
- LABORATORIO
- EQUIPOS
- Aspiradores
- Autoclaves - Esterilización
- Baños ultrasónicos y Lavadoras de instrumentos
- Crioterapia y contenedores criogénicos
- Dermatoscopia
- Ecografías
- Electrocirugía
- Lámparas médicas
- Microscopía
- Lentes de aumento
- Oftalmoscopios y otoscopios
- Saturímetros - Pulsioximetría
- Esfigmomanómetros
- Protecciones para tratamientos láser y UV
- Espirometría y Accesorios
- Estetoscopios / Fonendoscopios
- Herramientas para estética
- Visualizadores de venas LED
- Analisi sangue e urine
- Centrifughe
- Timpanometri
- SECTORES
- Área médica
- Cirugía general
- Dermatología
- Consumible para dermatología
- Agujas y jeringas
- Bisturí, hojas y cuchillas
- Tiritas, vendajes, apósitos y tiritas para suturas
- Criochirugía, crioterapia y termocauterios
- Curetas, punch, hojas para biopsia
- Desinfectantes y productos químicos
- Hilos de sutura
- Guantes y sábanas médicos
- Material para cirugía
- Peeling y needling (rodillo epidérmico)
- Protecciones para tratamientos láser
- Consumible para dermatología
- Ginecología
- Medicina estética
- Pediatría
- Emergencia y primeros auxilios
- Instrumentos quirúrgicos
- Fisioterapia
- Área médica
- AUXILIARES MÉDICOS
- Elettrodo
- MOBILIARIO
Catálogo Aptaca
APTACA
Dispositivos desechables y reutilizables para Laboratorios de Análisis, Hospitales, Institutos de Investigación, Veterinaria y para la Industria Química, Farmacéutica y Alimentaria.